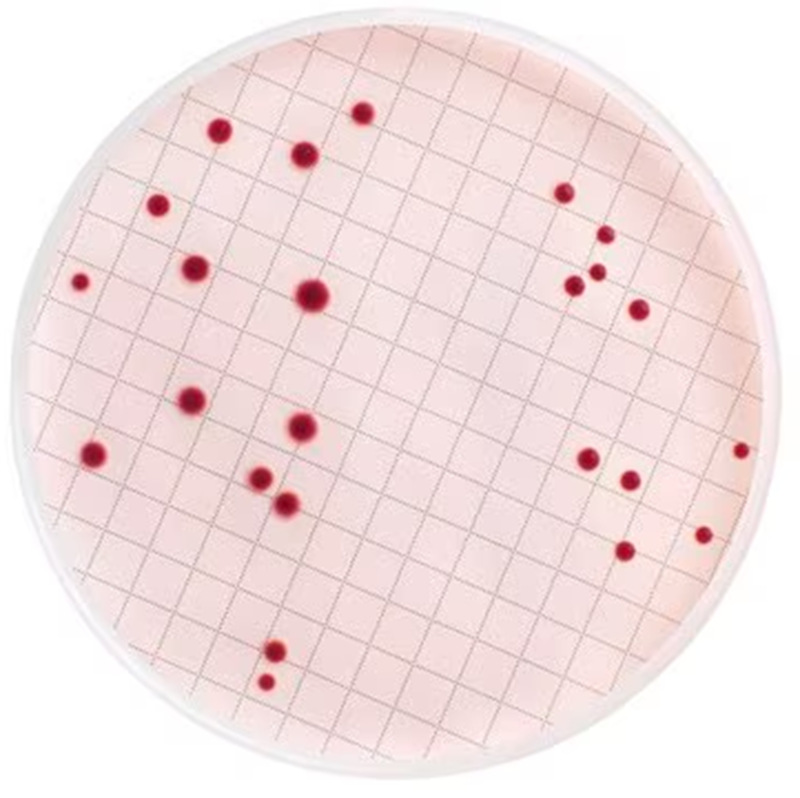

1688工业品为您提供在线免费查询更多化学试剂详细参数、实时报价、规格一览表。更多关于化学试剂多少钱一瓶/化学试剂报价明细/化学试剂规格型号价格表/化学试剂批发市场价格/化学试剂官方报价等咨询,尽在1688工业品。询底价>
为你找到其他化学试剂相关产品

扩散粉EBS10 进口韩国LG EBS分散剂 工程塑料色粉配色颜料润滑剂
广东东莞
在线询价

11330032 赛默飞 thermo DMEM/F-12,HEPES
福建福州
在线询价

5524-05-0 二氢香芹酮 96% 1kg 25kg 大/小包装供应 样品
湖北武汉
在线询价

阿拉丁试剂厂家直销 1662-01-7 红菲咯啉 化学实验多规格
上海
在线询价

丹磺酰氯 605-65-2 丹酰氯 样品 1kg 25kg 大小包装供应
湖北武汉
在线询价

魏氏试剂 对羟基苯甘氨酸—938-97-6 现货库存 质量保障
湖北武汉
在线询价
MB000000E Merck 默克 m-Endo总大肠菌群肉汤(脱水)
福建福州
在线询价

标准氦气厂家 10升实验室液氦碳钢包装 按需批发 万润达 g
湖北鄂州
在线询价

3-己烯酸乙酯 2396-83-0 香精香料 有机合成 样品整包装供应

湖北武汉
在线询价

硫代甜菜碱 DMT 7314-30-9 饲料添加剂 水产诱食剂 量大价优

湖北武汉
在线询价

现货供应 二氯乙酸钠 1kg/袋 2156-56-1 品质保障 含量99%
山东济南
在线询价

DDM(十二烷基-β-D-麦芽糖苷 69227-93-6 ) 样品整包装供应
湖北武汉
在线询价
查看更多产品及报价
100+其他化学试剂相关产品等你解锁
在线寻源3000行家正在找货
免费询价,源头正品,上1688工业品,全国的工业正品交易平台





